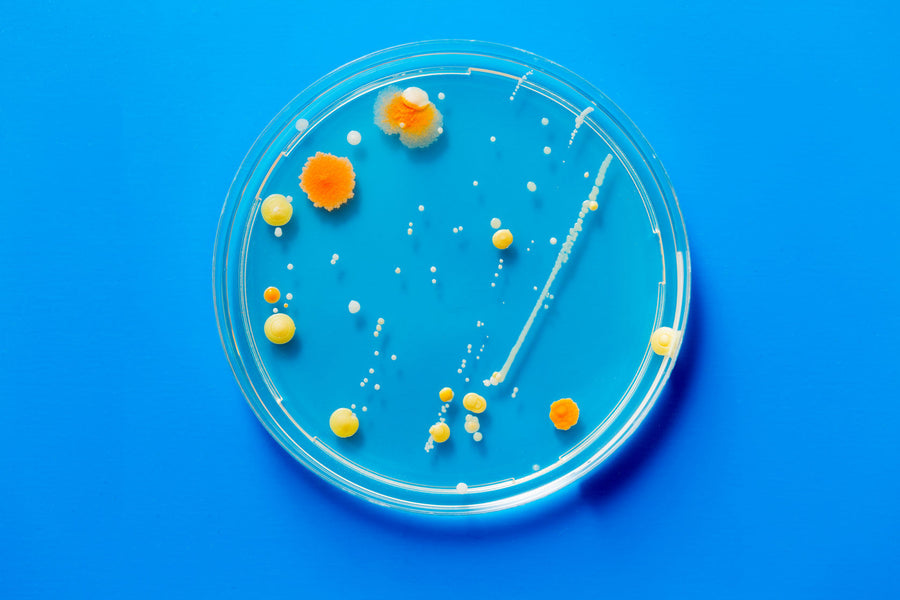

After being diagnosed with a chronic disease eleven years ago, I have a keen interest in following the latest discoveries being made by health researchers around the world. Regular readers will know that I dive with gusto into the evidence showing links between our health and our emotions, stress levels, relationships, beliefs, diet, sleep, exercise and daily habits. But of all the topics in health science that I closely follow, there is one that stands out as having the greatest potential to revolutionise the way we approach wellness and the treatment of chronic disease – the microbiome.
With thanks to new technology, scientists can now analyse the DNA of complex communities of bacteria that are found throughout your body. This has paved the way for new breakthroughs that have implications for the treatment of chronic diseases for which the traditional approach of drugs and surgeries are proving insufficient. Disruptions to the balance of your gut “wildlife” (a condition scientists call dysbiosis) is linked to obesity, diabetes, colon cancer, various inflammatory bowel conditions, and autoimmune diseases. According to the scientists at the frontier, the microbiome could play as powerful a role as genetics, lifestyle, and the environment in determining your health.
I recently spoke with Associate Professor Andrew Holmes from The Charles Perkins Centre at the University of Sydney, who is an expert on the link between our health and our microbes. (You can listen to the full interview in my podcast here.) He explained that how and why your gut microbes are connected to chronic disease is still largely a mystery but that one of the clues lies in their location. “The gut is arguably the major interface between our environment and the rest of our body. So if you think of the major body systems that are involved in basically regulating our normal functions – it’s the immune system, the endocrine system and the nervous system – and all three of those have their major sites of development in the gut,” he said.
We now know that there is a bi-directional conversation taking place between your gut bacteria and your body’s most important systems. For example, there is significant cross-talk between your gut bacteria and your immune cells. The bugs living in your gut can also receive and send signals that are passed to and from your brain. In other words, you can influence them, and they can influence you. In fact, Holmes explained, you have co-developed with your gut bugs.
In the first two or three years of life, your major bodily systems develop at the same time as your microbiome develops. “So they actually develop hand-in-hand and that’s one of the reasons we think that what happens in very early life has long lasting effects – because it shapes the way your body is going to respond to things for the rest of your life,” said Holmes. One example of this is the mounting evidence demonstrating that taking antibiotics at a young age not only results in killing off bad bugs causing infection, but also kills off friendly bugs. This disruption may explain the association between taking antibiotics and having allergies. “We’re disrupting that education pattern in terms of how the gut bugs and the immune system learn to work together,“ Holmes explained, emphasising that this is not an argument to suggest that all antibiotic use is problematic, but rather that we need to be highly aware of the potential for their overuse and their unnecessary use.
While this science is still very new, and every researcher I’ve spoken to about the microbiome-health links has done a significant amount of caveat-proclaiming hand-waving (check out my blog post on Probiotics – The Good The Bad and The Misleading for more on this), after chatting with Holmes, one take-away message really sunk home – We can no longer think of ourselves as an individual, but rather, as part of a dynamic ecosystem. As a mother of two young boys, my interview with Holmes also put a whole new spin on my job as a parent. I realised that I’m not only raising my kids, but that I’m also raising the bacterial wildlife living in their guts. “And not just raising their gut bugs,” Holmes added, “but actually teaching their body how to talk nicely to their gut bugs.”
Beyond any shadow of a doubt the main thing that affects gut bacteria is diet. Recently Holmes published a break-through paper which demonstrated that when we eat foods that encourage cooperation between ourselves and our bacteria, we achieve a good microbiome, but when we eat in a way that doesn't require cooperation, this lets bacteria do whatever they want – and mischief can ensue. It’s the people who lack diversity in their microbiomes who seem to be vulnerable to disease and the accumulating evidence suggests that the way to cultivate diversity is by eating a long-term, highly diverse, high-fibre diet. By eating a wide variety of fibrous plants, we are essentially feeding and encouraging a thriving, diverse population of bugs.
Isn’t it interesting that the science may be new and exciting but the the basic facts of nutrition had not changed in decades.
Further reading:
Is Your Microbiome the Key to Staying Healthy?
Food for Thought: How Gut Bugs Influence Your Mood
Probiotics – The Good, The Bad and The Misleading
Cut the Crap – How Junk Food Affects Your Gut
Listen to my podcast with Associate Professor Andrew Holmes: